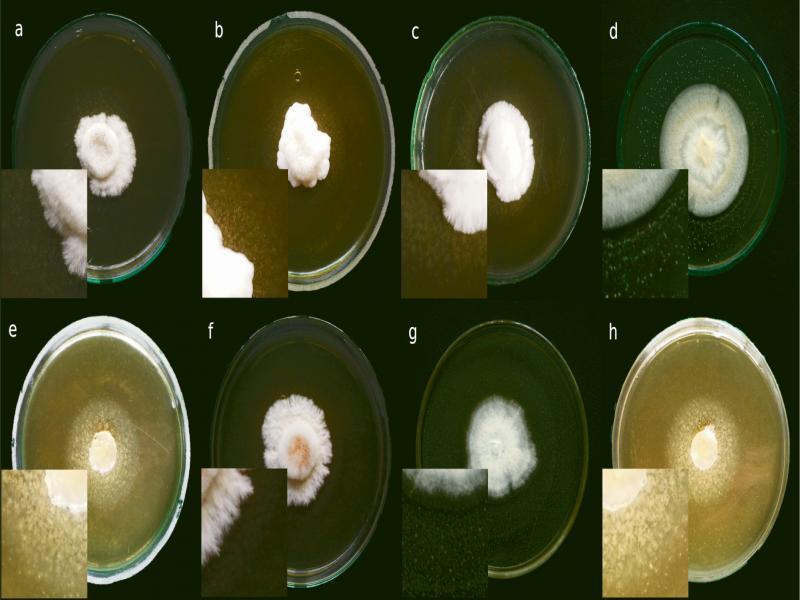

Various types of relationship between two or more organisms are well known among plants and in the animal kingdom. However, little is known about the relationship and interactions between fungi and bacteria. There are three most common types of these relationships. Bacteria can live in the same environment as fungi where both organisms live close to each other but not in direct contact. This kind of relationship is common in various environments like forests, fermented food or animal tissues affected by diseases (Frey-Klett et al. 2011). More complicated type of bacterial-fungal association is mixed biofilms, where bacteria may live on fungal hyphae and are held by the extracellular matrix formed from molecules secreted by both organisms (Donlan and Costerton 2002). This kind of coexistence can be found in medical equipment (Pierce 2005) as well as in some infections (Hogan et al. 2007) or mycorrhizal systems (Sarand et al. 1998). The third type of interactions between these two groups of organisms is endosymbiosis when bacteria live inside fungal cells and do not produce any specific structures. It is the most complex type of relationship and often, in contrast to free-living fungi-associated bacteria it is impossible to cultivate such bacteria outside a fungal host. The presence of unculturable endosymbiotic bacteria was described mostly in cells of arbuscular mycorrhizal fungi belonging to Gigasporaceae family (Bianciotto et al. 1996, 2000, 2003; Bonfante 2003; Cruz et al. 2008). The endosymbiotic bacteria were also observed in the cells of pathogenic fungus Rhizopus microsporus although in this case, authors were able to grow isolated bacteria on microbiological media (Partida-Martinez et al. 2007a; 2007b). Among Basidiomycota such relationship was found in Laccaria bicolor. Similarly to Gigaporaceae endosymbionts, these bacteria were also unculturable (Bertaux et al. 2003). Only one report described bacteria of Burkholderia cepacia complex related with oyster mushroom P. ostreatus. Authors, however, did not establish if these bacteria are endosymbionts or just fungi-related organisms (Yara et al. 2006).
The aim of this work was to identify bacteria associated with eight P. ostreatus strains, and also the description of their biodiversity and assessment of their ability for N2 fixation, cellulose, xylanase, and laccase-like multicopper oxidase activity.
Fungal strains. Eight strains from different geographical zones (PB63S, PBo6S, PxS, P234, P112 – Poland; PB7’96, PB8 – Japan, PUSAS – the USA) of P. ostreatus were analyzed. All strains were shared by the Department of Fruit, Vegetable and Mushroom Technology at the University of Life Sciences in Lublin. According to our knowledge, the strains analyzed were never cultivated on media containing antibiotics. Before experiments the fungal strains were cultivated for seven days in 28°C on Petri dishes with onion medium (onion extract 1000 ml (150 g of chopped onion boiled in 500 ml distilled H2O, filtered on cotton filter and filled with distilled H2O to 1000 ml, glucose 20 g, peptone 3 g, KH2PO4 1 g, MgSO4 0.5 g, agarose 20 g).
Observation of bacteria-like organisms associated with P. ostreatus. Observation of living bacteria-like organisms associated with fungal cells was carried out using a fluorescent microscope and a set of fluorescent dyes (Bianciotto et al. 2000). Total fungal mycelium from one Petri dish of every oyster mushroom strain cultivated for seven days was collected and grounded in a sterile glass mortar in 1 ml of sterile 0.1 M MgSO4. The obtained suspension was stained in a 50-μl volume with the fluorescent dye (Viability/Cytotoxicity Assay Kit for Bacteria, Biotium, USA) according to the manufacturer’s protocol. Observations were made using Nikon Eclipse 90i fluorescent microscope with the Omega XF25 filter. Pictures and videos were taken in the same conditions. The fluorescent kit used in the experiments is composed of two dyes. DMAO migrates through a cell membrane and stains double-stranded DNA of both living and dead bacteria on green or yellow-green color. The second dye, EthD-III migrates through damaged membranes of dead cells only and stains bacterial DNA on red color. This dye is stronger than DMAO and covers its color, thus dead bacteria are visible as red and live bacteria are visible as green or yellow-green organisms.
Isolation of organisms associated with P. ostreatus. Isolation of organisms associated with fungal strains was done from seven-days old fungal culture. The 16 mm diameter roundel was picked and placed mycelium towards to the medium on base and modified solid TSB medium (Sigma-Aldrich, USA), called later in this article as TSAt. The modification consisted of the addition of 1% of Tween 20 to the medium (ApliChem GmbH, Germany) as described by Yara et al. (2006). After 14 days of cultivation in 28°C, 25-mm2 square area of the solid medium with visible microcolonies was picked and placed in 50 ml of liquid TSBt medium (TSB with 1% of Tween 20) in Erlenmeyer flasks. Samples were cultivated for 14 days in 28°C stationary. After cultivation TSAt fragment was removed from samples and samples were centrifuged in 10 000 × g for 10 minutes. The supernatant was poured out and the precipitate was used for further experiments.
DNA isolation. Genomic DNA was extracted from precipitates using Genomic Mini AX Bacteria (A&A Biotechnology, Poland) according to the instructions of the manufacturer. The obtained DNA was purified with PowerClean DNA Clean-Up Kit (MO BIO Laboratories, Inc., USA) in accordance with the manufacturer’s protocol. Purified DNA was stored at −20°C for further experiments.
The identification of the associated organisms was performed using whole DNA isolated from fungal strains. Fresh fungal mycelia were harvested from 25 mm2 square area of the solid medium of 7 days old fungal colonies, then suspended and rubbed in 1 ml of 0.1 M MgSO4 in sterile glass mortars. Suspension in a volume of 100 μl of each fungal strain was used for DNA isolation using PowerSoil DNA Isolation Kit (MO-BIO Laboraories, Inc., USA) according to the manufacturer’s protocol. DNA was purified as described above.
16S rRNA amplification and identification. The confirmation of the bacterial nature of isolated microcolonies was carried out by determining the size of the 16S rRNA gene fragment by PCR. The reaction mixture contained isolated DNA, 2 × PCR RED Master Mix (DNA-GDANSK, Poland) kit, 799f, and 1492r primers, according to a procedure designed to distinguish bacteria and plant mitochondrial the 16S rRNA gene fragment as described by Chelius and Triplett (2001). DNA from Pseudomonas fluorescens PE16 strain was used as bacterial control. DNA isolated from maize cv. Cyrkon (Zea mays L.) was used as plant control. The controls were shared by the Agriculture Microbiology Lab at the Wroclaw University of Environmental and Life Sciences. The electrophoresis of the products obtained was performed (70 min, 100 V) on the agarose gel (0.8%) with 5% ethidium bromide. Bands were visualized in Dark Hood DH 40/50 and analyzed with Gelix-One 1D Software (Biostep GmbH, Germany).
The identification of bacteria was performed using a molecular cloning technique. Products of 16S rRNA PCR were purified with PCR SureClean Plus (Bioline LTD., UK) kit. Cloning was carried out with Zero Blunt PCR Cloning Kit (Life Technologies, USA) according to manufacturer’s protocol. The ligation mixture was prepared in 50:1 insert:vector ratio (250 ng of purified product), the ligation step was 30 minutes long. Competent E. coli TOP10 cells (Life Technologies, USA) were transformed with the ligand, spread on LB medium with 50 ppm of kanamycin and inoculated for 24 h in 37°C. Randomly 48 colonies, grown on plates, representing every analyzed fungal strain were picked up and inoculated on LB medium with 50 ppm of kanamycin in 96-well plates. Clones were incubated for 24 h in 37°C and sent to LGC Genomics (Berlin) for plasmids sequencing using the Sanger method with primer M13-29R (5’-CAGGAAACAGCTATGACC-’3). Because of unusual results of PUSAS strain, the clones’ identification procedure was repeated and 96 associated bacteria clones were sent for identification again. Sequences with the length of approximately 700 bp were analyzed using BLAST program in NCBI (USA) database. Sequences of clones identified to species or genus were deposited in NCBI database (Table I). Phylogenetic tree of the identified species or genus was build using the neighbor-joining method with maximum sequence difference set to 0.75. The tree was built in BLAST program and visualized in FigTree 1.4.3 (http://tree.bio.ed.ac.uk).
Accessing numbers of P. ostreatus clones sequences deposited in NCBI database with most similar strains from NCBI database.
| NCBI accessing number | Parent strain | Number of clones | The most similar strains in NCBI database | |
|---|---|---|---|---|
| Strain name | Accessing number and similarity (%) | |||
| KR779716 | PxS; PBo6S | 2 | Methylobacterium sp. 63 | JF905617 (99) |
| KR779718 | PBo6S | 1 | Corynebacterium ureicelerivorans IMMIB RIV-2301 | CP009215 (99) |
| KR779719 | PBo6S | 1 | Corynebacterium sp. clone YHSS1 | EF658675 (100) |
| KR779720 | PB8 | 1 | Corynebacterium sp. clone OD-12 | KX379256 (100) |
| KR779721 | PxS; PBo6S; PB7’96 | 4 | Weissella cibaria_BM2 | CP027427 (99) |
| MH424523 | P112 | 2 | Weissella confusa SM10 | KU060300 (100) |
| KR779722 | PBo6S; PB63S; P234; PxS | 5 | Paracoccus sp. clone SL36 | HQ264096 (100) |
| MH424529 | PB7’96 | 1 | Paracoccus yeei TWCC 57946 | LC371258 (100) |
| KR779723 | P234 | 1 | Bacillus sp. 1NLA3E | CP005586 (99) |
| KR779725 | PB7’96 | 1 | Bacillus sp. R-66632 | KT185191 (99) |
| KR779726 | P234; PB8; P112; PBo6S | 8 | Bacillus sp. CHORDb1 | MG995009 (100) |
| MH424530 | P112 | 2 | Bacillus sp. clone D | JX505089 (99) |
| MH424531 | PB8 | 1 | Bacillus megaterium Y103 | MH368091 (99) |
| KR779727 | PxS | 1 | Nocardioides_sp. clone EHFS1_S02a | EU071473 (100) |
| KR779728 | PBo6S; PB7’96 | 4 | Nocardioides terrigena DS-17 | NR_044185 (99) |
| KR779729 | PxS | 1 | Citricoccus sp. PL13f_S6 | JF274870 (99) |
| KR779730 | PxS | 1 | Micrococcus sp. EF1B-B144 | KC545358 (99) |
| MH424533 | P234 | 1 | Micrococcus luteus JGTA-S5 | KT805418 (99) |
| MH424534 | PB8 | 1 | Micrococcus sp. cpRA422 | KJ510213 (100) |
| MH424535 | P112 | 1 | Micrococcus sp. strain CAU1456 | MG214549 (99) |
| MH424536 | P234; PxS | 2 | Micrococcus terreus IHBB 9339 | KU921566 (99) |
| KR779731 | PxS; P112; PB7’96; P234; PB8 | 9 | Pelomonas saccharophila ATCC 15946 | NR_115049 (99) |
| KR779732 | P112; P234; PB8 | 5 | Staphylococcus epidermidis_FDAARGOS_161 | CP014132 (99) |
| MH424568 | PxS | 1 | Staphylococcus epidermidis TWSL_19 | KT184899 (100) |
| MH424569 | PxS | 1 | Staphylococcus caprae OZK14 | KT591476 (99) |
| MH424570 | P112 | 1 | Staphylococcus sp. JCE 11 | LT899997 (100) |
| MH424571 | PB8 | 1 | Staphylococcus sp. clone 12L_53 | KP183056 (99) |
| KR779733 | PB8; PBo6S | 2 | Ralstonia solanacearum RSCM | CP025986 (99) |
| MH426745 | PBo6S | 1 | Ralstonia sp. clone DVBSW_M180 | KF755496 (100) |
| KR779734 | PUSAS; PBo6S; P234; PB7’96; P112 | 11 | Cupriavidus metallidurans Ni-2 | CP026544 (100) |
| MH424572 | PBo6S | 1 | Cupriavidus sp. EF11(2012) | JX912460 (99) |
| KR779735 | PxS; P112 | 2 | Propionibacterium granulosum JCM 6498 | NR_113367 (99) |
| MH424575 | P112 | 1 | Propionibacterium sp. clone JPL-2_O14 | FJ957593 (99) |
| KR779736 | PB7’96; P112; PxS; P234; PB63S; Pbo6S | 11 | Propionibacterium sp. clone 12L_77 | KP183061 (99) |
| KR779737 | PxS; PB8; P234; P112 | 5 | Pseudomonas sp. 09C 129 | CP025261 (100) |
| KR779738 | PB7’96 | 1 | Pseudomonas _uorescens 2F9 | KT695813 (100) |
| MH424593 | PB7’96 | 2 | Pseudomonas__uorescens_PF85 | MF838663 (100) |
| MH424580 | PB8; PB63S | 2 | Pseudomonas simiae strain 4G1010 | KY939757 (100) |
| MH424594 | P112 | 1 | Pseudomonas _uorescens L228 | CP015639 (100) |
| MH424599 | PB7’96 | 1 | Pseudomonas lurida MYb11 | CP023272 (100) |
| KR779740 | P112; PB63S; PB7’96 | 4 | Acidovorax sp. clone M_KL_81_14 | KP967499 (100) |
| MH427201 | PB63S; PBo6S | 3 | Acidovorax sp. clone CSC28 | JN541150 (100) |
| KR779742 | PUSAS | 11 | Escherichia coli DA33137 | CP029579 (100) |
| MH427368 | PUSAS | 21 | Escherichia coli 2012C-4502 | CP027440 (100) |
| KR779743 | PUSAS | 31 | Escherichia coli 2015C-3125 | CP027763 (100) |
| MH427381 | PUSAS | 1 | Escherichia coli 2013C-3342 | CP027766 (100) |
| KR779745 | PxS | 1 | Lactobacillus sakei PR11 | KX139193 (99) |
| MH427585 | PxS | 1 | Lactobacillus sakei DS4 | CP025839 (99) |
| MH427654 | PB8 | 1 | Lactobacillus sakei FAM18311 | CP020459 (99) |
| KR779746 | PxS | 1 | Legionella sp. L-29 | AB856218 (98) |
| KR779747 | PxS | 1 | Finegoldia magna JCM 1766 | NR_113383 (99) |
| KR779748 | PxS | 1 | Sporosarcina psychrophila DSM 6497 | CP014616 (100) |
| KR779749 | PBo6S | 1 | Streptococcus pneumoniae 11A | CP018838 (99) |
| KR779750 | PB8 | 1 | Kocuria rhizophila 3330 | KP345929 (100) |
| KR779751 | PB8 | 1 | Lactococcus garvieae MJF010 | MH057260 (100) |
| KR779752 | P234 | 1 | Del_ia lacustris SH2 | MH014970 (100) |
| KR779753 | P234 | 1 | Pectobacterium carotovorum subsp. brasiliense BC1 | CP009769 (100) |
| KR779754 | P234 | 1 | Oryzihumus leptocrescens S32011-b | AB649006 (100) |
| KR779755 | P234 | 1 | Tumebacillus sp. 7B-408 | KF441681 (99) |
| KR779756 | P112 | 1 | Achromobacter mucicolens OZK37 | KT716268 (100) |
| KR779757 | PB7’96 | 1 | Herbaspirillum sp. WW2 | KU495919 (100) |
| MH427999 | P234; PBo6S; PB8; PB63S; PxS; PB7’96; P112 | 35 | Curvibacter sp. clone Z2_KL_466-12 | KP967473 (100) |
| MH428000 | PB63S, PB7’96; P112 | 3 | Curvibacter sp. clone CX 18.4 | KX260804 (99) |
| MH428038 | P234 | 1 | Acidobacteria clone SEW_08_293 | HQ598999 (99) |
| MH428102 | PB7’96 | 1 | Acidobacteria clone SEW_08_084 | HQ598816 (99) |
| MH428220 | P112 | 1 | Paenibacillus typhae xj7 | NR_109462 (99) |
| MH428377 | P112 | 1 | Paenibacillus marchantiophytorum R55 | NR_148618 (99) |
| MH428379 | P234 | 1 | Acinetobacter sp. SWBY1 | CP026616 (99) |
| MH428572 | P234 | 1 | Acinetobacter towneri MTCC11368T | KM070563 (99) |
| MH428659 | PBo6S | 1 | Streptomyces rishiriensis JCM 4686 | LC002811 (99) |
| MH428674 | PBo6S | 1 | Streptomyces sp. 111013air4 | KP262513 (99) |
| MH428833 | PB7’96 | 1 | Sphingomonas sp. CAU-S5 | MF113252 (99) |
NifH gene identification. The identification of NifH gene was performed by PCR with PolF and PolR primers according to the procedure described by Poly et al. (2001). The reaction mixture contained the tested DNA, 5 × Hot FIREPol Blend Master Mix buffer, and the primers mentioned above. Agarose gel electrophoresis of products was performed (agarose 2%, ethidium bromide 5%, electrophoresis time of 60 min, voltage 100 V). Products were visualized as described above. As a control, Azospirillum barsieliense 35Bb strain was used (Król and Perzynski 2005).
β-glucosidase gene identification. The identification of β-glucosidase gene was performed by PCR with bgluF and bgluR2 primers according to the procedure described by Canizares et al. (2011). The reaction mixture contained the isolated DNA, 5 × Hot FIRE-Pol Blend Master Mix buffer, and the primers mentioned above. Products visualization was performed as described above.
β-xylanase gene identification. For the identification of the β-xylanase gene, PCR was performed with XynF and XynR primers according to the procedure described by Khandeparker et al. (2011). The reaction mixture contained the isolated DNA, 5 × Hot FIRE-Pol Blend Master Mix buffer and the primers mentioned above. Products visualization was performed as described above.
LMCO genes identification. The identification of LMCO (laccase-like multicopper oxidase) genes was performed by PCR with Cu1AFand Cu2R primers according to the procedure described by Kellner et al. (2008). The reaction mixture contained the isolated DNA, 5 × Hot FIREPol Blend Master Mix buffer and the primers mentioned above. Products visualization was performed as described above.
A number of small bacteria-like organisms were observed inside and outside of cells of all analyzed oyster mushroom strains. They were visible as small green or yellow-green rods. The microscopic image is shown in Fig. 1. The bacteria-like organisms were marked with white arrows. Several of the cells observed were motile inside of fungal hyphae what is presented in materials published online (PxS – https://youtu.be/G93Rm0tHIgg; P234 – https://youtu.be/pxApJvCshQ0; PB7’96 – https://youtu.be/JZdGXSyDdG4; PB63S – https://youtu.be/A4U4MtUeIiU). After 10 days of cultivation, a lot of small objects were observed growing deeply in the medium around and outside fungal mycelia of all inoculates (Fig. 2). Such growth was not observed on TSA medium without addition of Tween 20. Tween 20 is used usually as a surfactant to disperse cells in solutions. Some of the bacteria also use Tween 20 as a source of fatty acids. No objects were observed in control samples that were not inoculated with fungi. Similar results were described previously by Yara et al. (2006). Blocks of media containing objects were used for cells isolation. After 14 days of stationary cultivation in the liquid TSBt medium, a white precipitate was observed on flasks bottom for all oyster mushrooms strains analyzed. After centrifugation, this precipitate was used for DNA amplification protocol.

Microscopic picture of analyzed oyster mushroom cells treated with fluorescent dyes under the fluorescent microscope. Strains: a) P234, b) PBo6S, c) PB8, d) P112, e) PB63S, f) PUSAS, g) PB7’96, h) PxS. Bacteria-like organisms, marked with white arrows, are visible as small green or yellow-green rods against fungal cells.
Bacteria-like organisms microcolonies growing deeply in TSAt medium after 10 days long cultivation. Strains: a) P234, b) PBo6S, c) PB8, d) P112, e) PB63S, f) PUSAS, g) PB7’96, h) PxS.
As a result of PCR performed with DNA obtained from precipitant and 799f and 1492r primers, a 700 bp product was obtained (Fig. 3). Product that size is characteristic only for bacterial DNA as it is a part of the bacterial 16S rRNA gene. For comparison, the reaction with maize DNA provided two bands: one of 1100 bp which is characteristic for plant mitochondrial DNA and second of size about 700 bp, characteristic for bacteria. The reason for this phenomenon is that maize cultivar used in experiment carry endophytic bacteria in its tissues (Pisarska and Pietr 2015).

Agarose gel electrophoresis showing products of PCR with 799f and 1942r primers of analyzed oyster mushroom, maize cv. Cyrkon (Zea mays L.) (line C) and bacterial strain Pseudomonas fluorescens PE16 (line PE16) DNA. The product of 700 bp is characteristic for bacterial 16S rRNA, the product of 1100 bp is characteristic for plant mitochondrial DNA. M – marker; B – blind control.
The total number of 307 sequences was obtained as a result of the sequencing of plasmid clones. The detailed number of identified clones with the most similar strains from NCBI database is presented in Table II. The species or genus was determined for 233 of them and for the remaining 74 sequences we were not able to identify higher taxonomic level than domena of Bacteria. All clones were identified only for PUSAS strain originated from the USA. Among other seven fungal strains, the unidentified clones occurred in the range from 7 to 15. Among tested strains of fungi, the lower biodiversity of bacteria was found for the strain PUSAS, which contained 64 clones closely related to E. coli and only two clones related to Cupriavidus genus. The only one genus, which occurred in all fungal strains analyzed but PUSAS, was Curvibacter and it was represented by 38 clones. Propionibacterium genus was found in six of eight fungal strains analyzed. It was not present only in PUSAS and PB8 strains. The total number of identified Propionibacterium strains was 14. Another genus found in six of P. ostreatus strains was Cupriavidus. It occurred in a total number of 13 clones in all fungal strains except PxS and PB63S. Bacteria belonging to genus Pseudomonas were also identified in a number of 12 clones from six fungal strains (except PUSAS and PBo6S). Genus Pelomonas was identified as nine clones from five fungal strains: P234, PB7’96, PB8, PxS, and P112. Bacteria from genus Paracoccus in a number of six were found in almost all of P. ostreatus strains from Poland (except P112). The remaining clones identified were as follows: Bacillus – 13 clones (in P234, PBo6S, PB8, P112), Staphylococcus – nine clones (in P234, PB8, PxS, P112), Acidovorax – seven clones (in PB7’96, PBo6S, PB63S, P112), Weisella – six clones (in PB7’96, PBo6S, PxS, P112), Micrococcus – six clones (in P234, PB8, PxS, P112), Nocardioides – five clones (in PB7’96, PBo6s, PxS), Ralstonia – three clones (in PBo6S, PB8), Corynebacterium – three clones (in PBo6S, PxS), Lactobacillus – three clones (in PBo6S, PxS), Acidobacteria – two clones (in P234, PB7’96), Paenibacillus – two clones (in P112), Acinetobacter – two clones (in P234), Streptomyces – two clones (in PBo6S), Legionella – one clone (PxS), Finegoldia – one clone (PxS), Sporosarcina – one clone (PxS), Streptococcus – one clone (PBo6S), Kocuria – one clone (PB8), Lactococcus – one clone (PB8), Delftia – one clone (P234), Pectobacterium – one clone (P234), Oryzihumus – one clone (P234), Tumebacillus – one clone (P234), Achromobacter – one clone (P112), Herbaspirillum – one clone (PB7’96), Citrococcus – one clone (PxS), Sphingomonas – one clone (PB7’96). The detailed number of identified clones with the most similar strains from NCBI database is presented in Table II. Phylogenetic tree of representatives of all identified genotypes with most similar sequences from NCBI database is presented in Fig. 4. As an out-group sequence, the Thermosipho sp. MV1063 (AJ419874) was used. The detailed number of identified clones with the most similar strains from NCBI database is presented in Table II.
Number and identification of clones obtained from analyzed P. ostreatus strains.
| Genus | Similarity based on 700 bp sequence of the 16S rRNA gene | Number of clones | Origin P. ostreatus strains | ||||||||
|---|---|---|---|---|---|---|---|---|---|---|---|
| The most closely related strain in NCBI | NCBI accession number(% of similarity) | USA | Japan | Poland | |||||||
| PUSAS | PB8 | PB7’96 | PBo6S | P234 | PxS | PB63S | P112 | ||||
| Escherichia | E. coli DA33137 | CP029579 (100) | 64 | 11 | 0 | 0 | 0 | 0 | 0 | 0 | 0 |
| E. coli 2012C-4502 | CP027440 (100) | 21 | 0 | 0 | 0 | 0 | 0 | 0 | 0 | ||
| E. coli 2015C-3125 | CP027763 (100) | 31 | 0 | 0 | 0 | 0 | 0 | 0 | 0 | ||
| E. coli 2013C-3342 | CP027766 (100) | 1 | 0 | 0 | 0 | 0 | 0 | 0 | 0 | ||
| Curvibacter | Curvibacter sp. clone Z2_KL_466-12 | KP967473 (100) | 38 | 0 | 6 | 8 | 4 | 6 | 4 | 2 | 5 |
| Curvibacter sp. clone CX 18.4 | KX260804 (99) | 0 | 0 | 1 | 0 | 0 | 0 | 1 | 1 | ||
| Propionibacterium | Propionibacterium sp. clone 12L_77 | KP183061 (100) | 14 | 0 | 0 | 1 | 1 | 2 | 2 | 2 | 3 |
| P. granulosum JCM 6498 | 113367 (99) | 0 | 0 | 0 | 0 | 0 | 1 | 0 | 1 | ||
| Propionibacterium sp. clone JPL-2_O14 | FJ957593 (99) | 0 | 0 | 0 | 0 | 0 | 0 | 0 | 1 | ||
| Bacillus | Bacillus sp. CHORDb1 | MG995009 (100) | 13 | 0 | 2 | 0 | 1 | 2 | 0 | 0 | 3 |
| Bacillus sp. clone D | JX505089 (99) | 0 | 0 | 0 | 0 | 0 | 0 | 0 | 2 | ||
| Bacillus sp. 1NLA3E | CP005586 (99) | 0 | 0 | 0 | 0 | 1 | 0 | 0 | 0 | ||
| Bacillus sp. R-66632 | KT185191 (99) | 0 | 0 | 1 | 0 | 0 | 0 | 0 | 0 | ||
| Bacillus megaterium Y103 | MH368091 (99) | 0 | 1 | 0 | 0 | 0 | 0 | 0 | 0 | ||
| Cupriavidus | C. metallidurans Ni-2 | CP026544 (100) | 12 | 2 | 2 | 1 | 3 | 2 | 0 | 0 | 2 |
| Cupriavidus sp. EF11(2012) | JX912460 (99) | 0 | 0 | 0 | 1 | 0 | 0 | 0 | 0 | ||
| Pseudomonas | Pseudomonas sp. 09C 129 | CP025261 (100) | 12 | 0 | 2 | 0 | 0 | 1 | 1 | 0 | 1 |
| P. fuorescens PF85 | MF838663 (100) | 0 | 0 | 2 | 0 | 0 | 0 | 0 | 0 | ||
| P. simiae 4G1010 | KY939757 (100) | 0 | 1 | 0 | 0 | 0 | 0 | 1 | 0 | ||
| P. fuorescens L228 | CP015639 (100) | 0 | 0 | 0 | 0 | 0 | 0 | 0 | 1 | ||
| P. fuorescens 2F9 | KT695813 (100) | 0 | 0 | 1 | 0 | 0 | 0 | 0 | 0 | ||
| P. lurida MYb11 | CP023272 (100) | 0 | 0 | 1 | 0 | 0 | 0 | 0 | 0 | ||
| Staphylococcus | S. epidermidis FDAARGOS_161 | CP014132 (99) | 9 | 0 | 1 | 0 | 0 | 2 | 0 | 0 | 2 |
| S. epidermidis TWSL_19 | KT184899 (100) | 0 | 0 | 0 | 0 | 0 | 1 | 0 | 0 | ||
| S. caprae OZK14 | KT591476 (99) | 0 | 0 | 0 | 0 | 0 | 1 | 0 | 0 | ||
| Staphylococcus sp. JCE 11 | LT899997 (100) | 0 | 0 | 0 | 0 | 0 | 0 | 0 | 1 | ||
| Staphylococcus sp. clone 12L_53 | KP183056 (100) | 0 | 1 | 0 | 0 | 0 | 0 | 0 | 0 | ||
| Pelomonas | P. saccharophila ATCC 15946 | NR_115049 (99) | 9 | 0 | 2 | 1 | 0 | 2 | 3 | 0 | 1 |
| Acidovorax | Acidovorax sp. clone M_KL_81_14 | KP967499 (100) | 4 | 0 | 0 | 1 | 0 | 0 | 0 | 1 | 2 |
| Acidovorax sp. clone CSC28 | JN541150 (100) | 3 | 0 | 0 | 0 | 1 | 0 | 0 | 2 | 0 | |
| Weissella | W. cibaria BM2 | CP027427 (99) | 6 | 0 | 0 | 1 | 2 | 0 | 1 | 0 | 0 |
| W. confusa SM10 | KU060300 (100) | 0 | 0 | 0 | 0 | 0 | 0 | 0 | 2 | ||
| Micrococcus | M. luteus JGTA-S5 | KT805418 (100) | 6 | 0 | 0 | 0 | 0 | 1 | 0 | 0 | 0 |
| Micrococcus sp. cpRA422 | KJ510213 (100) | 0 | 1 | 0 | 0 | 0 | 0 | 0 | 0 | ||
| Micrococcus sp. EF1B-B144 | KC545358 (99) | 0 | 0 | 0 | 0 | 0 | 1 | 0 | 0 | ||
| Micrococcus sp. strain CAU1456 | MG214549 (99) | 0 | 0 | 0 | 0 | 0 | 0 | 0 | 1 | ||
| M. terreus IHBB 9339 | KU921566 (99) | 0 | 0 | 0 | 0 | 1 | 1 | 0 | 0 | ||
| Paracoccus | Paracoccus sp. clone SL36 | HQ264096 (100) | 6 | 0 | 0 | 0 | 1 | 1 | 2 | 1 | 0 |
| P. yeei TWCC 57946 | LC371258 (100) | 0 | 0 | 1 | 0 | 0 | 0 | 0 | 0 | ||
| Nocardioides | N. terrigena DS-17 | NR_044185 (99) | 5 | 0 | 0 | 2 | 2 | 0 | 0 | 0 | 0 |
| Nocardioides sp. clone EHFS1_S02a | EU071473 (99) | 0 | 0 | 0 | 0 | 0 | 1 | 0 | 0 | ||
| Ralstonia | R. solanacearum RSCM | CP02598 (99) | 3 | 0 | 1 | 0 | 1 | 0 | 0 | 0 | 0 |
| Ralstonia sp. clone DVBSW_M180 | KF755496 (100) | 0 | 0 | 0 | 1 | 0 | 0 | 0 | 0 | ||
| Corynebacterium | C. ureicelerivorans IMMIB RIV-2301 | CP009215 (99) | 3 | 0 | 0 | 0 | 1 | 0 | 0 | 0 | 0 |
| Corynebacterium sp. clone YHSS1 | EF658675 (100) | 0 | 0 | 0 | 1 | 0 | 0 | 0 | 0 | ||
| Corynebacterium sp. clone OD-12 | KX379256 (100) | 0 | 1 | 0 | 0 | 0 | 0 | 0 | 0 | ||
| Lactobacillus | L. sakei FAM18311 | CP020459 (99) | 3 | 0 | 0 | 0 | 1 | 0 | 0 | 0 | 0 |
| L. sakei PR11 | KX139193 (99) | 0 | 0 | 0 | 0 | 0 | 1 | 0 | 0 | ||
| L. sakei DS4 | CP025839 (99) | 0 | 0 | 0 | 0 | 0 | 1 | 0 | 0 | ||
| Acidobacteria | Acidobacteria clone SEW_08_293 | HQ598999 (99) | 2 | 0 | 0 | 0 | 0 | 1 | 0 | 0 | 0 |
| Acidobacteria clone SEW_08_084 | HQ598816 (99) | 0 | 0 | 1 | 0 | 0 | 0 | 0 | 0 | ||
| Paenibacillus | P. typhae xj7 | NR_109462 (99) | 2 | 0 | 0 | 0 | 0 | 0 | 0 | 0 | 1 |
| P. marchantiophytorum R55 | NR_148618 (99) | 0 | 0 | 0 | 0 | 0 | 0 | 0 | 1 | ||
| Acinetobacter | Acinetobacter sp. SWBY1 | CP026616 (99) | 2 | 0 | 0 | 0 | 0 | 1 | 0 | 0 | 0 |
| A. towneri MTCC11368T | KM070563 (99) | 0 | 0 | 0 | 0 | 1 | 0 | 0 | 0 | ||
| Streptomyces | S. rishiriensis JCM 4686 | LC002811 (99) | 2 | 0 | 0 | 0 | 1 | 0 | 0 | 0 | 0 |
| Streptomyces sp. 111013air4 | KP262513 (99) | 0 | 0 | 0 | 1 | 0 | 0 | 0 | 0 | ||
| Legionella | Legionella sp. L-29 | AB856218 (98) | 1 | 0 | 0 | 0 | 0 | 0 | 1 | 0 | 0 |
| Finegoldia | F. magna JCM 1766 | NR_113383 (99) | 1 | 0 | 0 | 0 | 0 | 0 | 1 | 0 | 0 |
| Sporosarcina | S. psychrophila DSM 6497 | CP014616 (100) | 1 | 0 | 0 | 0 | 0 | 0 | 1 | 0 | 0 |
| Streptococcus | S. pneumoniae 11A | CPO18838 (99) | 1 | 0 | 0 | 0 | 1 | 0 | 0 | 0 | 0 |
| Kocuria | K. rhizophila 3330 | KP345929 (100) | 1 | 0 | 1 | 0 | 0 | 0 | 0 | 0 | 0 |
| Lactococcus | L. garvieae MJFO10 | MH057260 (100) | 1 | 0 | 1 | 0 | 0 | 0 | 0 | 0 | 0 |
| Delfia | D. lacustris SH2 | MHO 14970 (100) | 1 | 0 | 0 | 0 | 0 | 1 | 0 | 0 | 0 |
| Pectobacterium | P. carotovorum subsp. brasiliense BC1 | CP009769 (100) | 1 | 0 | 0 | 0 | 0 | 1 | 0 | 0 | 0 |
| Oryzihumus | O. leptocrescens S32011-b | AB649006 (100) | 1 | 0 | 0 | 0 | 0 | 1 | 0 | 0 | 0 |
| Tumebacillus | Tumebacillus sp. 7B-408 | KF441681 (99) | 1 | 0 | 0 | 0 | 0 | 1 | 0 | 0 | 0 |
| Achromobacter | A. mucicolens OZK37 | KT716268 (100) | 1 | 0 | 0 | 0 | 0 | 0 | 0 | 0 | 1 |
| Herbaspirillum | Herbaspirillum sp. WW2 | KU495919 (100) | 1 | 0 | 0 | 1 | 0 | 0 | 0 | 0 | 0 |
| Citricoccus | Citricoccus sp. PL13f_S6 | JF274870 (99) | 1 | 0 | 0 | 0 | 0 | 0 | 1 | 0 | 0 |
| Sphingomonas | Sphingomonas sp. CAU-S5 | MF113252 (99) | 1 | 0 | 0 | 1 | 0 | 0 | 0 | 0 | 0 |
| Number of diferent clones | X | X | X | 5 | 15 | 16 | 17 | 18 | 17 | 8 | 17 |
| Number of genus | X | X | 32 | 2 | 9 | 13 | 13 | 15 | 13 | 5 | 12 |
| Number of unidentified clones of Bacteria | X | X | 74 | 0 | 6 | 10 | 14 | 10 | 15 | 7 | 12 |

Phylogenetic tree of identified bacteria associated with P. ostreatus strains representatives and most similar to them sequences from NCBI database. As an outgroup sequence Thermosipho sp. MV1063 (AJ419874) was used. The scale bar represents the number of changes per nucleotide position. Accession numbers are given at the end of each sequence.
The PCR reactions designed for detection of NifH, β-glucosidase and β-xylanase genes gave no product for all analyzed fungal strains. However, LMCO genes were detected (Fig. 5). LMCO is a complex of enzymes, which include laccases (EC 1.10.3.2) among others.

Agarose gel electrophoresis showing products of PCR with Cu1AF and Cu2R primers and analyzed oyster mushroom DNA. Visible 140 bp band represents amplified LMCO genes. M – marker; B – blind control.
Yara et al. (1999, 2006) reported that bacteria or bacteria-like organisms could interact with only one strain of P. ostreatus. However, authors did not confirm the endocellular character of these bacteria, they described them only as bacteria associated with P. ostreatus G2 hyphae. Using fluorescent microscopy technique, which was described by Bianciotto et al. (2000), we found bacteria associated with all eight tested strains of P. ostreatus originating from different geographic zones (Japan, Poland, and the USA). Every specimen was prepared from living cells and their movement was possible to observe under a microscope. These observations and lack of growth of isolated organisms without the presence of host on microbiological media strongly suggested the endosymbiotic character of the observed bacteria. This hypothesis was also strongly supported by the fact that cultivation of the fungal strains on media with wide range of antibacterial antibiotics (ampicillin, neomycin, gentamicin, penicillin G, streptomycin, polymyxin B, kanamycin, ciprofloxacin, detreromycin, tobramycin (200 ppm), meropenem, and ceftadizine (30 ppm), data unpublished) did not eradicate bacteria from fungal mycelia. Similar techniques used for the isolation of bacteria from five strains of Lentinula edodes not revealed the presence of associated bacteria (data unpublished). Due to the fact that it was not possible to fully distinguish between endosymbiotic and associated bacteria among the isolates tested we decided to use in this study the term “bacteria associated with”. Literature of subject shows the presence of one or two species of bacteria associated with P. ostreatus. Yara et al. (2006) described bacteria associated with one strain of P. ostreatus belonging to B. cepacia complex, which is complex of at least 20 different species from Burkholderia genus (LiPuma 2005). In this work, we report the presence of bacteria related to at least 34 different genera living in association with eight P. ostreatus strains originating from different geographical regions. It was noticeable that bacteria from genus Curvibacter were isolated from almost all analyzed fungal strains. The only one strain that did not contain these bacteria was a PUSAS strain. This strain also was the only one associated with E. coli bacteria what is difficult to explain due to lack of knowledge of history of this strain, The bacteria from the Curvibacter genus were reported endosymbionts of Oryza sativa roots (Singh et al. 2006), similarly as an uncultured bacterium from Chlorella cultures (Otsuka et al. 2008) and tomato rhizosphere (Lioussanne et al. 2010) and the bacteria associated with Hydra, which serve as a protective factor against pathogen infections (Fraune et al. 2015). Bacteria of genera Bacillus and Pseudomonas are well-known plant growth-promoting bacteria due to competitive and antagonistic activity versus several pathogens (Compant et al. 2010). The occurrence of Curvibacter, Bacillus and Pseudomonas bacteria associated with P. ostreatus could be related to the known lower susceptibility of this edible mushroom when compare to Agaricus bisporus (J.E. Lange) Imbach. Gigasporacea sp. endosymbionts were described as N2 fixing bacteria (Bianciotto et al. 2003). However, our study did not show the presence of nitrogenase reductase genes using PolF and PolR primers; however, the occurrence of clones similar to Cupriavidus suggest that these bacteria could be N2-fixers associated with oyster mushroom. Strains of Cupriavidus taiwanensis, previously were isolated from nodules of Mimosa, can nodulate also legumes and fix N2. However, the nifH gene is only distantly related to other alphaproteobacterial rhizobial strains (Gyaneshwar et al. 2011), what was probably a reason that used primers were not specific in this case. The bacteria associated with P. ostreatus could also influence their hosts’ capability for lignocellulolytic substrates utilization. PCR reactions with specific primers for β-glucosidase, β-xylanase genes did not reveal their presence, which suggests that these bacteria did not play important role in degradation of polysaccharides. However, the presence of LMCO genes was identified in this study. Laccases are a group of enzymes able to use a variety of substrates, including lignin (Rekuc et al. 2006). This suggests that although oyster mushroom-associated bacteria were able to produce neither β-glycosidase nor β-xylanase, they still could be able to support the lignocellulolytic activity of the strains tested due to laccase activity.
The origin of identified P. ostreatus-associated bacteria, their phylogenesis, and relationship with hosts were difficult to determine. In the natural environment, the oyster mushroom is a saprophyte, which develops on dead trunks and deciduous trees. Occasionally, it can develop in places of cuts on living trees. Such a variety of hosts may be the reason for the biodiversity of bacterial associations. Different non-pathogenic species probably inhabited mycelium of P. ostreatus during colonization of various hosts.